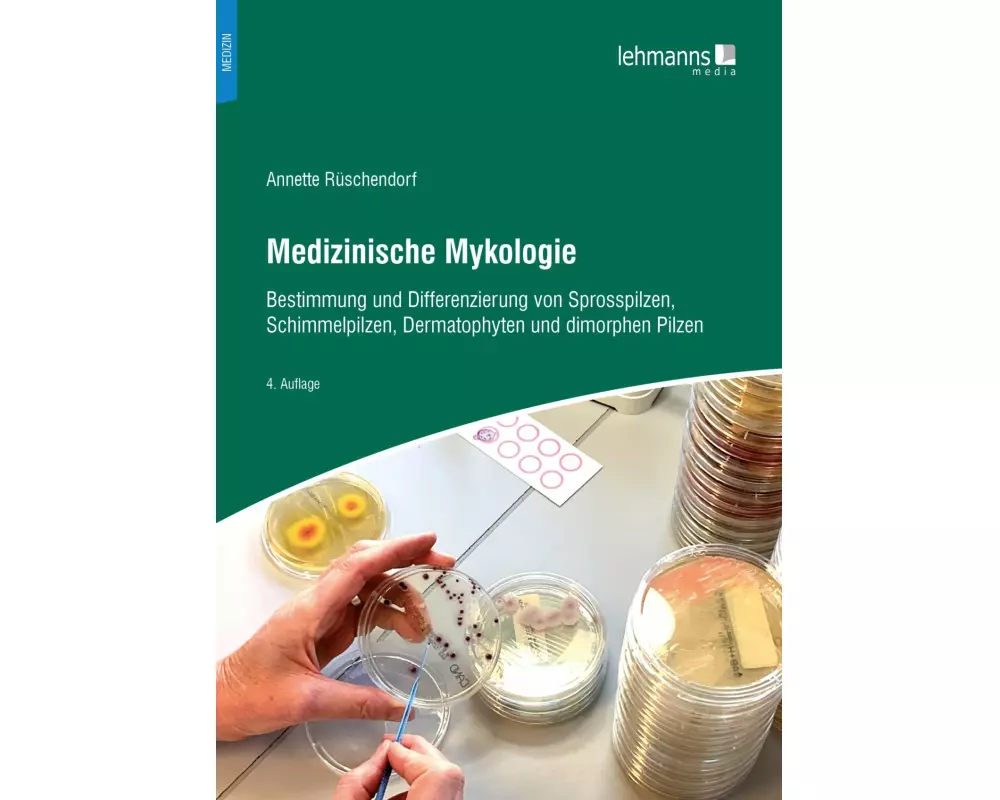
Medizinische Mykologie

Marke: Lehmanns
Hier finden Sie zu den besten Preisen alle Produkte der Marke Lehmanns.
Bestellungen bis 17:00 Uhr für Produkte auf Lager erhalten Sie - ohne Versandgebühr - am nächsten Werktag.
1
Meistgekauft
Auf Lager:
2
Inklusive LeseFibel
für Kinder mit Down-Syndrom, Leseratten und Legastheniker
CHF 31.01
2
Meistgekauft
Erhältlich:
Nicht auf Lager
Medizinische Mykologie
Bestimmung und Differenzierung von Sprosspilzen, Schimmelpilzen, Dermatophyten und dimorphen Pilzen
CHF 31.01
3
Meistgekauft
Erhältlich:
Nicht auf Lager
Fachsprache in der Zahnmedizin
CHF 31.40
4
Auf Lager:
3
Die anatomische Präparation von Hund und Katze
Eine unterstützende Anleitung für Studierende der Veterinärmedizin
-2.5 %
CHF 51.21